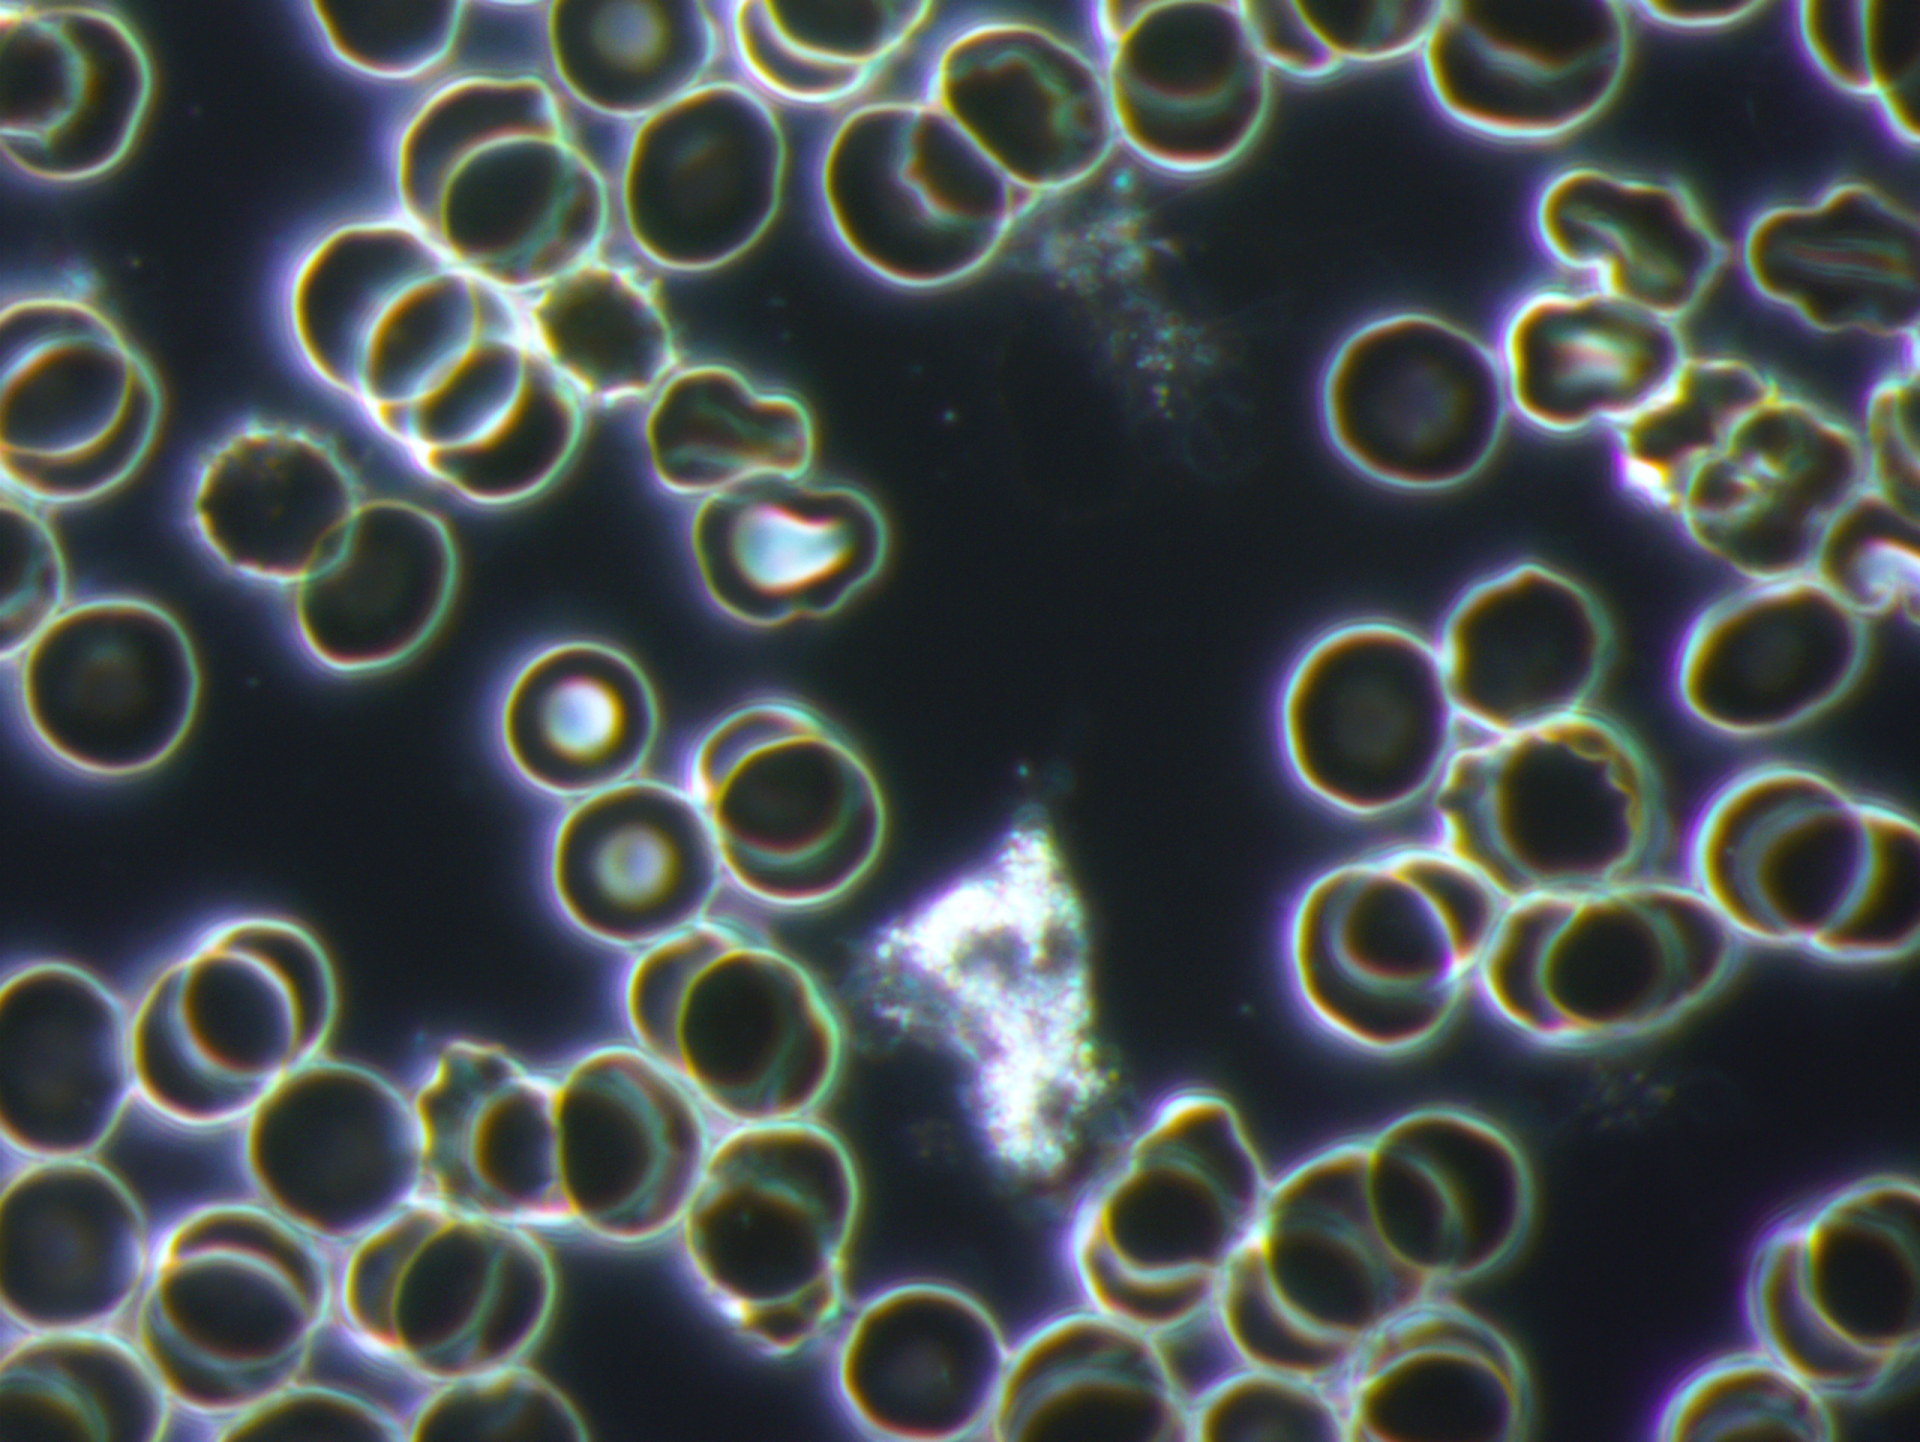

Willkommen
auf der Seite meiner Praxis für Naturheilkunde
Über meine Praxis
Hier erfahren Sie mehr über meine Arbeit als Heilpraktikerin
-
Diagnosen
Schaltfläche -
Therapien
Schaltfläche -
Praxis
Button
Mehr anzeigen
Der direkte Kontakt zur Praxis
Für Fragen oder Terminwünsche können Sie gerne eine Nachricht schreiben oder Sie rufen an unter:
Tel. 09441 / 685 88 20
Kontaktieren Sie uns
Vielen Dank, dass Sie sich an mich gewendet haben.
Ich setzen mich so schnell wie möglich mit Ihnen in Verbindung.
Tut uns leid. Beim Senden Ihrer Nachricht ist ein Fehler aufgetreten.
Bitte versuchen Sie es später noch einmal.
Bitte versuchen Sie es später noch einmal.